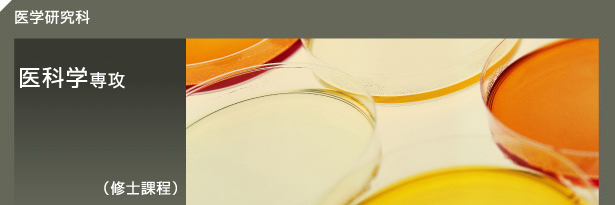
wȁ@ȊwUiCmےj

|

| |
医学研究科医科学専攻は、医学研究科の中にあって修士の養成を目標としている、日本国内では数少ないプログラムの一つとして、その存在が注目を集めています。
|


|
人体構造機能学・病理学・感染症学・臨床医学といった医学部の教育科目も多数準備してあり、人文社会系の背景を持つ学生であっても学生は自分の目的に合った科目を自由に選択し、医学の基本知識を学ぶことができるよう配慮がなされています。もちろん、分子細胞生物学・免疫学・医学情報学など基礎系を重点的に学べる科目も用意しており、このような幅広い科目を履修することによって、学生の医学知識は充実され、修士課程修了時には医学研究科博士課程へ進学し医学研究者への道を進むことができるようにカリキュラムが構成されています。
また、修士課程修了後、高度専門職として社会に出る学生のための教育も充実させ、医学の専門知識は当然のことながら、他方で分子細胞生物学・免疫学・医学情報学・社会医学・国際医療学・分子生体制御学及び精神保健学などの科目を準備し、薬などの開発のための臨床試験のコーディネーターあるいは国際医療などの領域で社会貢献できるようにプログラムが作られています。したがって、本医科学修士課程は、医学分野とそれ以外の分野の橋渡しをする役割をも担っているといえるでしょう。

|

|